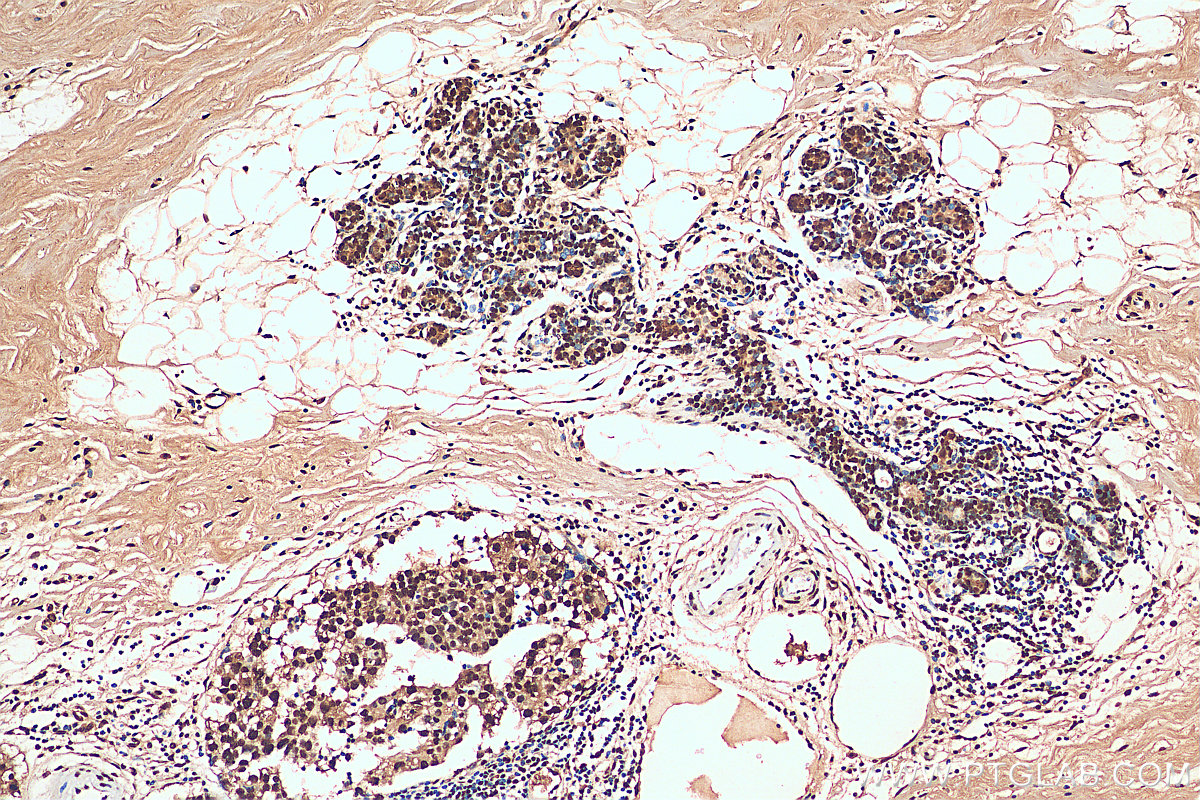

验证数据展示
经过测试的应用
| Positive WB detected in | HeLa cells, mouse colon tissue, K-562 cells, Neuro-2a cells, C6 cells |
| Positive IHC detected in | mouse pancreas tissue, human breast cancer tissue, human colon tissue, human colon cancer tissue, human liver cancer tissue, human lung cancer tissue Note: suggested antigen retrieval with TE buffer pH 9.0; (*) Alternatively, antigen retrieval may be performed with citrate buffer pH 6.0 |
| Positive IF/ICC detected in | HeLa cells |
推荐稀释比
| 应用 | 推荐稀释比 |
|---|---|
| Western Blot (WB) | WB : 1:5000-1:50000 |
| Immunohistochemistry (IHC) | IHC : 1:500-1:2000 |
| Immunofluorescence (IF)/ICC | IF/ICC : 1:50-1:500 |
| It is recommended that this reagent should be titrated in each testing system to obtain optimal results. | |
| Sample-dependent, Check data in validation data gallery. | |
产品信息
11176-1-AP targets HNRNPA1 in WB, IHC, IF/ICC, IP, CoIP, RIP, ELISA applications and shows reactivity with human, mouse, rat, pig samples.
| 经测试应用 | WB, IHC, IF/ICC, ELISA Application Description |
| 文献引用应用 | WB, IHC, IF, IP, CoIP, RIP |
| 经测试反应性 | human, mouse, rat, pig |
| 文献引用反应性 | human, mouse, rat, pig, zebrafish |
| 免疫原 |
CatNo: Ag1656 Product name: Recombinant human HNRNPA1 protein Source: e coli.-derived, PGEX-4T Tag: GST Domain: 1-320 aa of BC009600 Sequence: MSKSESPKEPEQLRKLFIGGLSFETTDESLRSHFEQWGTLTDCVVMRDPNTKRSRGFGFVTYATVEEVDAAMNARPHKVDGRVVEPKRAVSREDSQRPGAHLTVKKIFVGGIKEDTEEHHLRDYFEQYGKIEVIEIMTDRGSGKKRGFAFVTFDDHDSVDKIVIQKYHTVNGHNCEVRKALSKQEMASASSSQRGRSGSGNFGGGRGGGFGGNDNFGRGGNFSGRGGFGGSRGGGGYGGSGDGYNGFGNDGSNFGGGGSYNDFGNYNNQSSNFGPMKGGNFGGRSSGPYGGGGQYFAKPRNQGGYGGSSSSSSYGSGRRF 种属同源性预测 |
| 宿主/亚型 | Rabbit / IgG |
| 抗体类别 | Polyclonal |
| 产品类型 | Antibody |
| 全称 | heterogeneous nuclear ribonucleoprotein A1 |
| 别名 | HNRPA1, hnRNP core protein A1, hnRNP A1, Heterogeneous nuclear ribonucleoprotein A1, N-terminally processed, Helix-destabilizing protein |
| 计算分子量 | 34 kDa |
| 观测分子量 | 34, 40 kDa |
| GenBank蛋白编号 | BC009600 |
| 基因名称 | HNRNPA1 |
| Gene ID (NCBI) | 3178 |
| RRID | AB_2117177 |
| 偶联类型 | Unconjugated |
| 形式 | Liquid |
| 纯化方式 | Antigen affinity purification |
| UNIPROT ID | P09651 |
| 储存缓冲液 | PBS with 0.02% sodium azide and 50% glycerol, pH 7.3. |
| 储存条件 | Store at -20°C. Stable for one year after shipment. Aliquoting is unnecessary for -20oC storage. |
背景介绍
In eukaryotic cells, nascent RNA polymerase II transcripts are associated in the nucleus with specific proteins to form ribonucleoprotein complexes called HNRP or 40S. Protein moiety of the HNRP particle has 6 major components called core proteins, and HNRPA1 is one of them. hnRNP A1 is a multifunctional RNA binding protein which is involved in pre-mRNA splicing, export of mature transcripts from the nucleus, mRNA turnover, and internal ribosome entry site (IRES)-mediated translation. HNRNPA1 has three isoforms with MW 30 kDa, 34 kDa and 39 kDa.
实验方案
| Product Specific Protocols | |
|---|---|
| IF protocol for HNRNPA1 antibody 11176-1-AP | Download protocol |
| IHC protocol for HNRNPA1 antibody 11176-1-AP | Download protocol |
| WB protocol for HNRNPA1 antibody 11176-1-AP | Download protocol |
| Standard Protocols | |
|---|---|
| Click here to view our Standard Protocols |
发表文章
| Species | Application | Title |
|---|---|---|
Cell In vivo structural characterization of the SARS-CoV-2 RNA genome identifies host proteins vulnerable to repurposed drugs. | ||
Mol Cell Zc3h13 Regulates Nuclear RNA m6A Methylation and Mouse Embryonic Stem Cell Self-Renewal. | ||
Mol Cell A Peptide Encoded by a Putative lncRNA HOXB-AS3 Suppresses Colon Cancer Growth.
| ||
Nat Commun Profiling PRMT methylome reveals roles of hnRNPA1 arginine methylation in RNA splicing and cell growth.
| ||
Mol Biol Evol Long-term artificial selection reveals a role of TCTP in autophagy in mammalian cells. | ||
J Cell Biol An APEX2 proximity ligation method for mapping interactions with the nuclear lamina. |